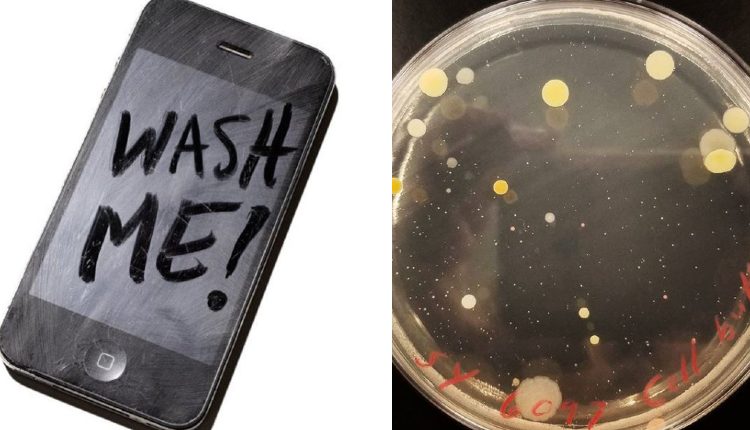

¡Asqueroso! Celulares están más contaminados que la taza de baño
Después de leer esto ya no verás de la misma forma a los no tan inocentes celulares, pues resulta que son más sucios que una taza de baño.
Sí, así como lo lees, en la superficie de estos dispositivos se encuentra un cultivo digno de ser analizado por especialistas. ¿No lo crees? Sigue leyendo.
De acuerdo con un estudio elaborado por el Instituto Mexicano del Seguro Social (IMSS) los celulares tienen hasta 18 veces más gérmenes.
Asi que ya sabes, la próxima vez que toques tu celular recuerda llevar contigo cantidades industriales de gel antibacterial o toallas desinfectantes.
Te podría interesar: Brillo excesivo del celular casi deja ciega a una adolescente
Así es como los celulares son un ambiente idóneo para los gérmenes
En entrevista para El Universal, la coordinadora del IMSS, Brenda Ramírez, reveló que el celular puede ser aún más dañino que ir a un baño público.
Cuando no limpias tu celular en un buen rato puede hacerse el más nocivo cultivo de difteroides, estafilococo y estreptococo.
Debido a que los celulares tienen una superficie tibia, es muy fácil que se reproduzcan en su cubierta.
Sanitizar, lavar y asolear fundas de celulares es elemental para evitar cualquier clase de enfermedad.
“Lavarse las manos adecuadamente varias veces al día para evitar traspasar las bacterias, limpiar el celular frecuentemente con un paño húmedo”, expresó Ramírez Vega como medidas de cuidado.